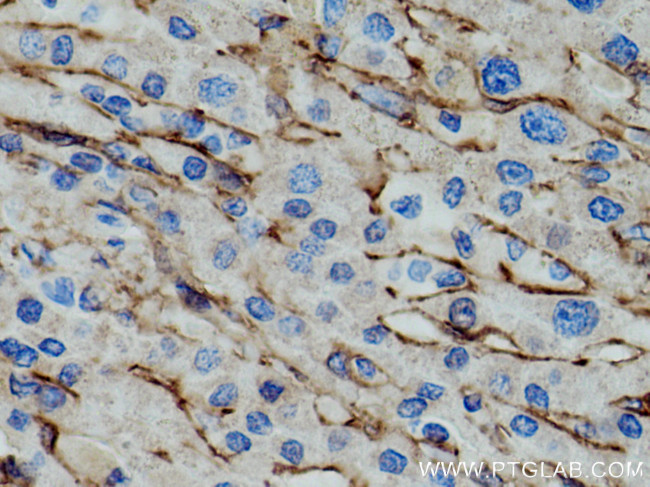
AOC3 Antibody in Immunohistochemistry (Paraffin) (IHC (P))

Search
Proteintech
AOC3 Monoclonal Antibody (2A6G3)
{{$productOrderCtrl.translations['antibody.pdp.commerceCard.promotion.promotions']}}
{{$productOrderCtrl.translations['antibody.pdp.commerceCard.promotion.viewpromo']}}
{{$productOrderCtrl.translations['antibody.pdp.commerceCard.promotion.promocode']}}: {{promo.promoCode}} {{promo.promoTitle}} {{promo.promoDescription}}. {{$productOrderCtrl.translations['antibody.pdp.commerceCard.promotion.learnmore']}}
产品信息
66834-1-IG
种属反应
宿主/亚型
分类
类型
克隆号
抗原
偶联物
形式
浓度
规格
纯化类型
保存液
内含物
保存条件
运输条件
产品详细信息
Aliquoting is unnecessary for -20°C storage.
靶标信息
Copper amine oxidases catalyze the oxidative conversion of amines to aldehydes in the presence of copper and quinone cofactor. The product is a major protein on the adipocyte plasma membrane. It has adhesive properties and also has functional monoamine oxidase activity. A pseudogene for this gene has been discribed and is located approximately 9-kb downstream.
仅用于科研。不用于诊断过程。未经明确授权不得转售。
生物信息学
蛋白别名: Amine oxidase [copper-containing] 3; Amine oxidase copper-containing 3; amine oxidase, copper containing 3 (vascular adhesion protein 1); Copper amine oxidase; HPAO; membrane primary amine oxidase; placenta copper monamine oxidase; Semicarbazide-sensitive amine oxidase; SSAO; unnamed protein product; VAP-1; Vascular adhesion protein 1
基因别名: AOC3; HPAO; SSAO; VAP-1; VAP1
UniProt ID: (Human) Q16853
Entrez Gene ID: (Human) 8639